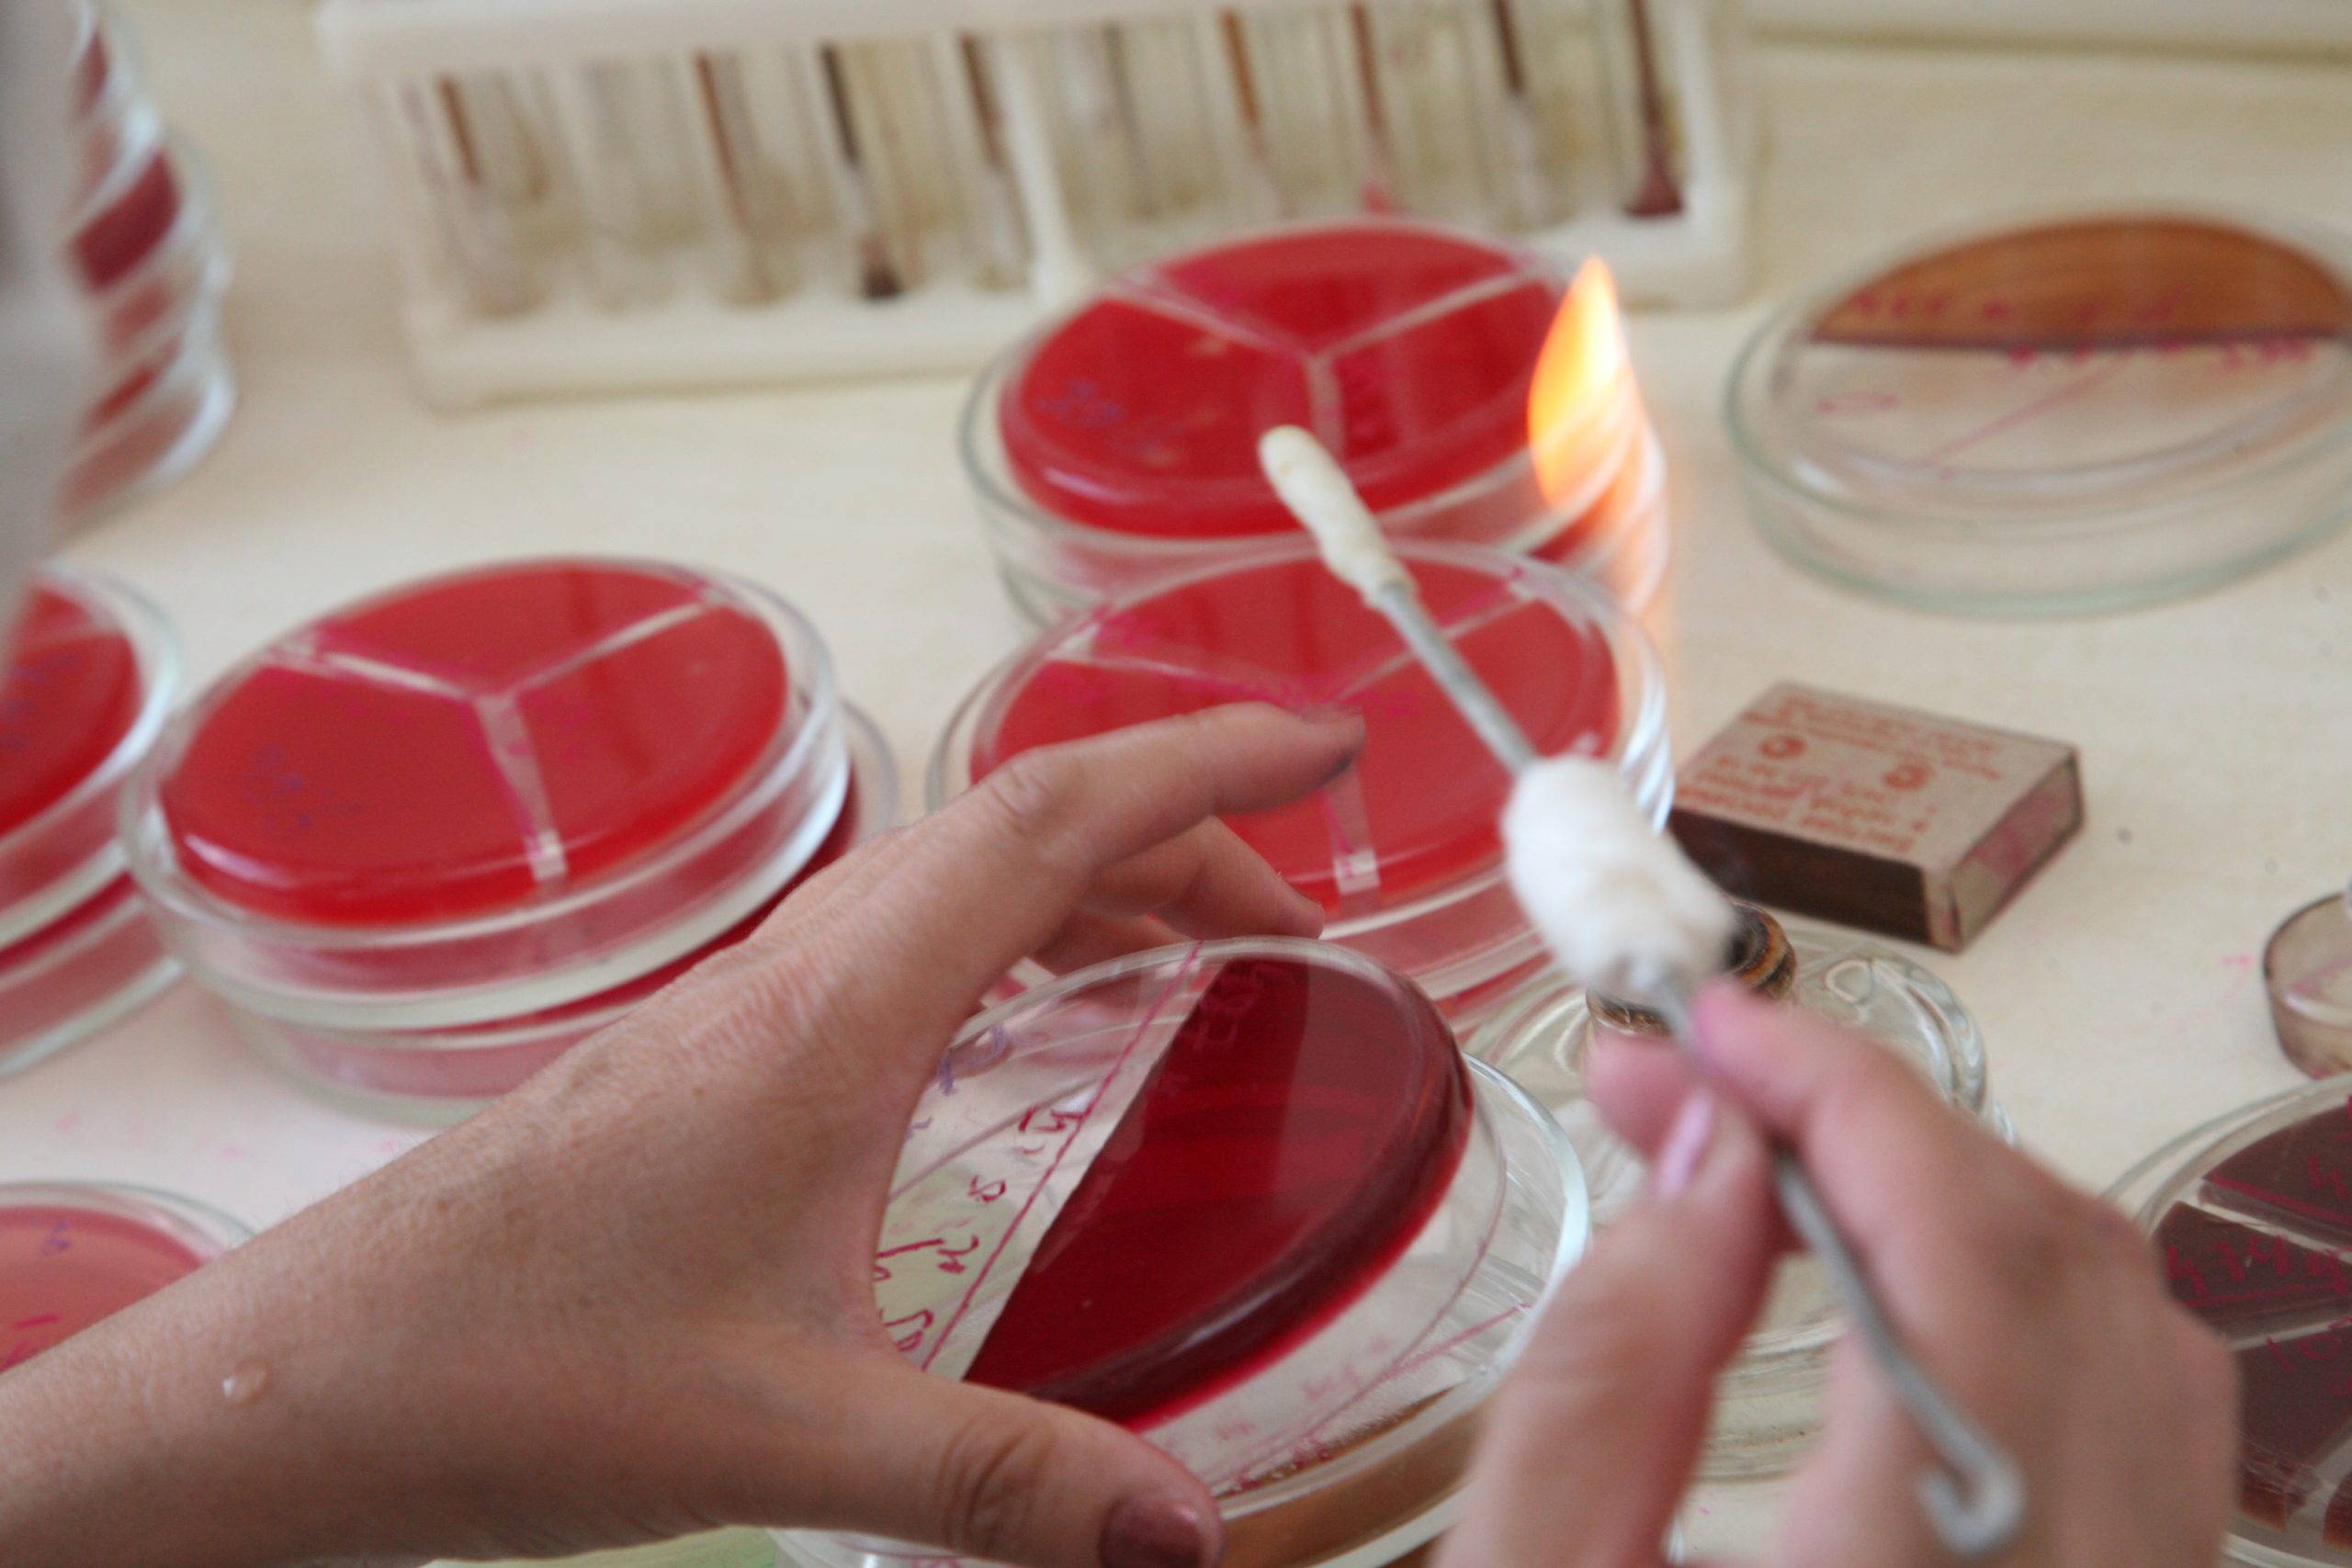

Выпавших из ОСМС активно трудоустраивают, чтобы они могли получить полный пакет медицинской помощи. За тех, кто оказался в зоне риска, заплатят из бюджета.
В Караганде под председательством заместителя акима области Ораза Таурбекова состоялось заседание Регионального штаба по вопросам медстрахования.
Несмотря на то что отмечается положительная динамика вовлеченности населения в государственную систему соцзащиты в сфере охраны здоровья, все еще немало тех, кто уклоняется от ежемесячных взносов. Таких граждан, конечно, не оставят без помощи в экстренных случаях, но рассчитывать они смогут только на базовый минимум.
Как отметил директор филиала НАО «Фонд социального медицинского страхования» Фазыл Копобаев, в системе ОСМС застрахованы 960 364 человека, что составляет 84,8%.
«Предстоит получить статус «Застрахован» около 172 тысячам жителей. Неплохая динамика снижения количества граждан, которые были вне системы, отмечается в Шахтинске, Каркаралинском, Шетском и Актогайском районах», — пояснил спикер.
Чтобы исправить ситуацию, акиматам городов и районов поручено активнее вовлекать жителей в обязательное социальное медицинское страхование. В частности, содействовать в трудоустройстве, взять на контроль предприятия и организации, чтобы работники могли получать полный комплекс медуслуг.
Стоит отметить, что с 2026 года за безработных граждан, оказавшихся в кризисной и экстренной категории, взносы в Фонд медстрахования будут оплачивать из местного бюджета. В Карагандинской области таких порядка 50 тысяч.
Светлана СБРОДОВА
Фото из архива «ИК»